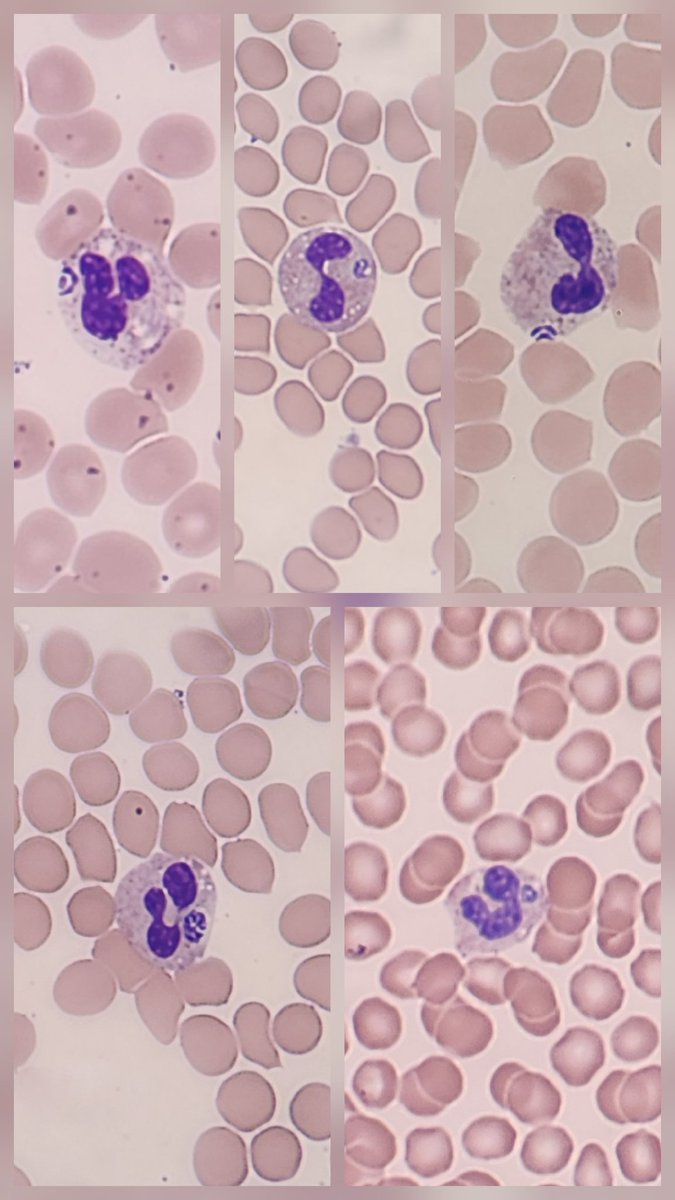
Marc Couturier PhD, D(ABMM) 🕷🦠🔬 tweet media

Marc Couturier PhD, D(ABMM) 🕷🦠🔬
379 posts

Marc Couturier PhD, D(ABMM) 🕷🦠🔬
@Parasite_Power
A clinical microbiologist/parasitologist sharing the love of parasites for the Twitterverse. Images and opinions are my own. NorDx Lab, MaineHealth.
Scarborough, ME Katılım Ağustos 2020
45 Takip Edilen1.6K Takipçiler
Marc Couturier PhD, D(ABMM) 🕷🦠🔬 retweetledi

This was amazing work by an amazing team! Happy to see it rolling out and changing the game!
ARUP Laboratories@ARUPLabs
Parasitology had been technologically stagnant for decades until ARUP changed the game. Now, ARUP leverages AI to improve detection of GI parasites and ease the laborious testing process. Learn more: ow.ly/z8JE50Wct5W #parasitology #parasites #artificialintelligence
Scarborough, ME 🇺🇸 English

Happy Medical Laboratory Professionals Week 2025 to all my amazing lab folks!
Keep doing the amazing "dirty" work that nobody else sees. 🧪🧫🧬💩
🤜🔬🤛
@NorDxLab
Maine, USA 🇺🇸 English

This was a very fun experience to present 5 years of work in just a few minutes. But the audience was great and the discussions with colleagues afterwards was very enriching. The AI movement is huge in microbiology. The more work and the more experiences, the better it will be!
ARUP Laboratories@ARUPLabs
Marc Couturier, PhD, will present on the development of an AI-screening tool designed to detect human gastrointestinal parasites in wet-mount slides at ESCMID in Vienna, Austria. Learn more about how the tool has improved detection: ow.ly/WCao50VAzpL
Vienna, Austria 🇦🇹 English

@SBtotheDub @ASMicrobiology ASTMH had a very similar and resolute statement to members. Nice to see leadership, strength, representation of membership, and courage.
Take notes indeed!
English

@StephenTristram @ARUPLabs I took the images from the routine O&P that was sent to us. I do not have any clinical information except that the patient was from "Appalachia" and was REALLY sick. No PMH or underlying diagnosis provided. Just very sick was all we were provided with.
English

@Parasite_Power @ARUPLabs This is an amazing image. I've seen free-living females in really old stool before, but these look like parasitic females that should be in the mucosa. Do you have any more information about the image or the patient it came from?
English

When is Strongy, too much Strongy? Well, anytime...
But especially...when moms look like they are taking their kids out to the park to play!?
Three adult female Strongy and numerous L1 larvae. So much Strongy!
#parasitology
@ARUPLabs

English

This was a fun. The worm was barely recognizable as a worm. It vaguely looked like a proglottid, but the specimen was badly degraded. Clearing the tissue with some lactophenol exposed the genus-level ID. Taenia eggs in utero. Hooklets visible even!
#Parasitology
@ParasiteGal

English

journals.asm.org/doi/10.1128/jc…
Super excited for this new work our team published (Dr. Angela Ma now at Public Health Ontario & Blaine Mathison at ARUP!). UV autofluorescence microscopy is a great tool that I share pictures of here often 💡🔬🪩
#parasitology
@ParasiteGal
@ARUPLabs
English
Marc Couturier PhD, D(ABMM) 🕷🦠🔬 retweetledi

Great turnout of Lab Directors for the #clinicalmicrobiology meet up and possibly future interest group. Thanks @aharrington1884 and @ISDA for setting this up, was great!! 😊 #IDWeek2024

English

@SBtotheDub Completely inaccurate and difficult to control, manual, human, subjective method. But yeah, A.I. is a problem... 🤦🏻♂️
English

Completely bonkers that FDA isn’t going to regulate things like comp fix but WILL require labs to comply with all the regulatory requirements for things like automating a manual process in an LDT. Great talk from Dr Relegeno #SCASM2024

English

Friday, Funday. This is what we consider...a whole lot of Dientamoeba fragilis! Mostly binucleate forms with variably fragmented karyosomes.
#parasitology @ARUPLabs @ParasiteGal



English

@ARUPLabs @ParasiteGal These are larvae of Ixodes sp. One might assume I. scapularis based on geography, but the necessary features to key out larvae to species are difficult to discern.
English

Fun treat today in the lab. A bunch of ticks from Ohio, each smaller than a poppy seed. Looks like a skydiving formation 😆.
✔️ No eyes
✔️ Long mouthparts
✔️ Inverted anal groove
✔️ 6 legs.
How would you report?
#parasitology
@ARUPLabs @ParasiteGal


English

@girlneedsanap @ARUPLabs @ParasiteGal Ixodes larvae is correct! Well done. Likely I. scapularis, but hard to key out to species with just larvae.
English

@Parasite_Power @ARUPLabs @ParasiteGal Would have to be larvae. It's a guess since I don't have all my resources in front of me!
English